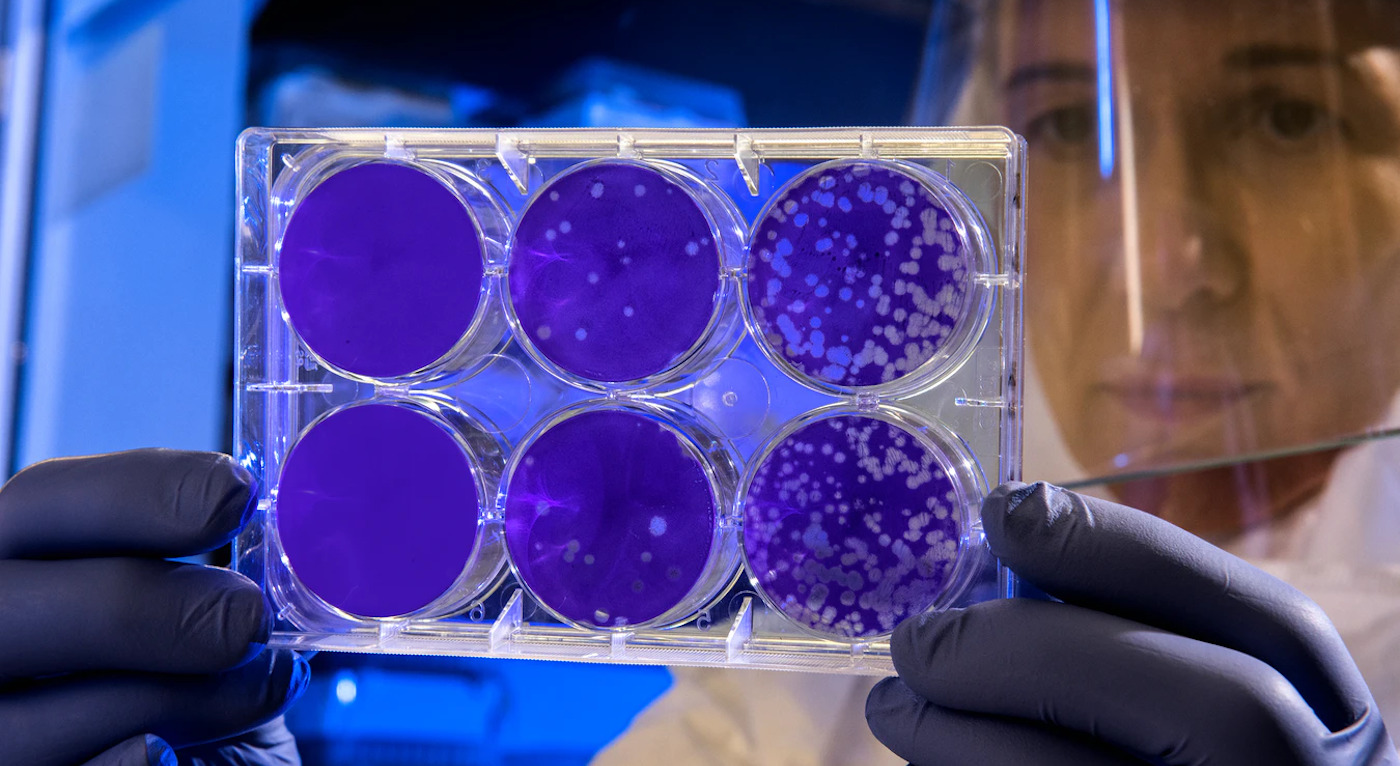

Quote of the Day: “In times of widespread chaos and confusion, it has been the duty of more advanced human beings—artists, scientists, clowns and philosophers—to create order.” Tom Robbins (turns 88 today)
Photo: by CDC (growing flu cells)
With a new inspirational quote every day, atop the perfect photo—collected and archived on our Quote of the Day page—why not bookmark GNN.org for a daily uplift?